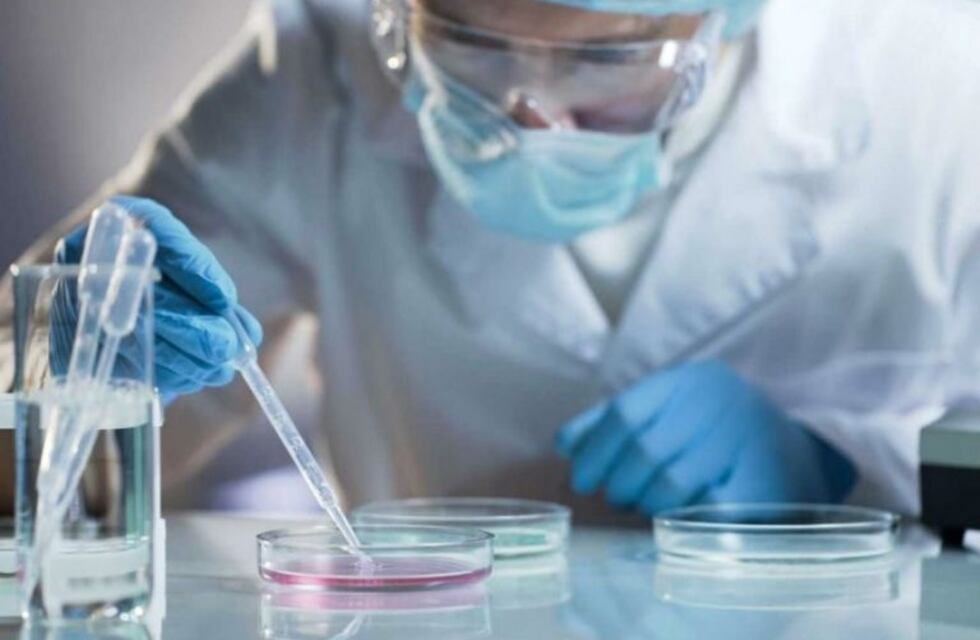
Mendoza sumó tres nuevos casos positivos de coronavirus y un fallecido

Mendoza sumó tres nuevos casos positivos de coronavirus, un fallecido, sumando un total de 62 infectados. Por otra parte, este martes se dieron tres altas. El deceso de un hombre de 85 años, fue en el Hospital Regional de Malargüe.
El Ministerio de Salud, Desarrollo Social y Deportes de Mendoza informó:
* Un hombre de 31 años con nexo epidemiológico de haber estado en Colombia. Fue internado el 26 de marzo en el hospital Lencinas.
* Una mujer de 50 años con nexo epidemiológico de haber estado en Perú: internada en hospital Lencinas el 28 de marzo.
* Un hombre de 32 años con nexo epidemiológico por contacto estrecho con postivo COVID-19. El paciente es profesional de la Salud y fue internado el 3 abril en la Clínica de Cuyo.
Además se informó que este martes se procesaron 49 determinaciones, de las cuales 46 fueron negativas. Los pacientes negativos están en los hospitales: 14 Clínica Francesa; 6 Hospital Schestakow; 5 Hospital Central; 4 Hospital Regional de Malargüe; 3 Hospital Español; 2 Hospital Perrupato; 2 Hospital Lagomaggiore; 2 Hospital Santa Isabel Hungría; 5 Hospital Enfermeros Argentinos, y el resto en los hospitales Español de San Rafael, Notti, Santa Clara y Hospital Privado Asimismo, se informan 3 nuevos casos positivos: Un hombre de 90 años por contacto estrecho con positivo de COVID-19. Se encuentra internado en el Hospital Privado.